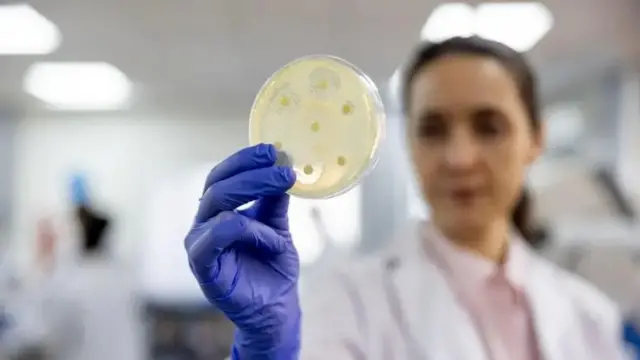
فنگل

’قاتل فنگس‘ کیا ہے؟ جان لیوا فنگل انفیکشن سے خود کو کیسے محفوظ رکھا جائے؟

،تصویر کا ذریعہGetty Images
- مصنف, انکوائری پوڈ کاسٹ
- عہدہ, بی بی سی ورلڈ سروس
- مطالعے کا وقت: 11 منٹ
جب آپ موسمیاتی تبدیلی کا لفظ سنتے ہیں تو ذہن میں کیا تصویر آتی ہے؟ زیادہ تر لوگ بڑھتے ہوئے درجہ حرارت، طوفان، گلیشیئر پگھلنے، جنگل کی آگ اور زراعت کو پہنچنے والے نقصان کے بارے میں سوچتے ہیں۔
لیکن موسمیاتی تبدیلی کا ایک اور اثر بھی ہے جس پر شاذ و نادر ہی بات کی جاتی ہے۔ بڑھتے ہوئے درجہ حرارت کے باعث فنگل سے ہونے والی بیماریوں میں اضافہ ہو رہا ہے، یعنی وہ بیماریاں جو فنگل یا بیکٹریا سے ہوتی ہیں۔
دلچسپ بات یہ ہے کہ موسمیاتی تبدیلی کے باعث سرد علاقوں میں بھی جہاں پہلے فنگس عام طور پر نہیں پائی جاتی تھی، اب ان علاقوں میں بھی اس نے پنپنا شروع کر دیا ہے۔
مانچسٹر یونیورسٹی کی تحقیق کے مطابق، ’ڈیڈلی‘ فنگس کا پھیلاؤ جو پہلے صرف گرم ممالک میں پایا جاتا تھا اب یورپ تک پھیل سکتا ہے۔ یہ فنگس ایسپرجیلوسس کا سبب بنتی ہے جو ایک پھیپھڑوں کی بیماری ہے اور جس کی وجہ سے ہر سال دنیا بھر میں تقریباً 18 لاکھ افراد موت کا شکار ہوتے ہیں۔
ایک اندازے کے مطابق یہ بیماری اب افریقہ اور جنوبی امریکہ سے شمالی ممالک تک پھیل رہی ہے۔
امریکہ کی مینیسوٹا یونیورسٹی سے منسلک سنٹر فار انفیکٹیو ڈیزیز اینڈ ریسرچ پالیسی کی ایک تحقیق کے مطابق انڈیا میں بھی ہر سال ڈھائی لاکھ افراد ایسپرجیلوسس کا شکار ہوتے ہیں جن میں ٹی بی جیسی بیماریوں میں مبتلا مریضوں کا تناسب بہت زیادہ ہے۔
اس بیماری کا تذکرہ حال ہی میں ٹی وی شو ’دی لاسٹ آف ہم‘ میں کیا گیا تھا، جس میں ایک فنگل بیماری لوگوں کے دماغوں کو نقصان پہنچاتی ہے اور انھیں زومبی میں تبدیل کر دیتی ہے۔
اگر ہم مبالغہ آرائی نہ بھی کریں تو پھپھوندی کی بیماریاں یقیناً تشویش کا باعث بن چکی ہیں۔ تو ہم خود کو ایسی قاتل فنگس سے کیسے بچا سکتے ہیں؟
End of سب سے زیادہ پڑھی جانے والی
ہمارے ارد گرد فنگس
بی بی سی اردو کی خبروں اور فیچرز کو اپنے فون پر حاصل کریں اور سب سے پہلے جانیں پاکستان اور دنیا بھر سے ان کہانیوں کے بارے میں جو آپ کے لیے معنی رکھتی ہیں
سبسکرائب کرنے کے لیے کلک کریں
مواد پر جائیں
اڈیلیا وارس برطانیہ کی یونیورسٹی آف ایکسیٹر میں بچوں کے متعدی امراض کی پروفیسر ہیں۔
وہ کہتی ہیں کہ فنگل یا پھپھوندی کے جراثیم ہمارے ارد گرد ہر جگہ موجود ہوتے ہیں۔ چونکہ مٹی میں پھپھوندی پائی جاتی ہے، اس لیے اس کے جراثیم ہوا کے ذریعے میلوں تک سفر کر سکتے ہیں۔
ہم نے ان سے پوچھا کہ فنگل بیماری کی وضاحت کیسے کی جائے۔
ایڈیلیا کا اس بارے میں کہنا ہے کہ ’فنگل بیماریاں فنگس پیتھوجینز کی وجہ سے ہوتی ہیں۔ یہ بیماریاں بیکٹیریا اور وائرس سے ہونے والی بیماریوں سے ملتی جلتی ہیں۔‘
انھوں نے کہا کہ ’کھلاڑیوں کے پاؤں جیسی فنگل بیماریاں صرف ہلکی تکلیف کا باعث بنتی ہیں لیکن کچھ فنگل مرض دماغ کو بھی متاثر کر سکتے ہیں اور جان لیوا بھی ہو سکتے ہیں۔ فنگس جلد کی بیماریوں کا سبب بن سکتی ہے۔‘
وہ کہتے ہیں کہ ’فنگس کے جراثیم ارد گرد کے ماحول سے ناخنوں، خاص طور پر پیر کے ناخنوں تک پھیل سکتے ہے۔‘
ایتھلیٹس کے پاؤں میں خارش، لالی، پیروں کی جلد کی خشکی، اور انگلیوں پر زخم جیسی علامات کا مطلب ہوتا ہے کہ وہ فنگس کے جراثیم کا شکار ہو چکے ہیں۔
اگر آپ کے پیروں کے تلوے پھٹے ہوئے ہیں تو فنگس آسانی سے وہاں رہائش اختیار کر سکتی ہے۔ اگرچہ یہ کچھ تکلیف کا باعث بن سکتا ہے، لیکن اس کا عام طور پر آپ کی صحت پر کوئی سنگین اثر نہیں پڑتا ہے۔
لیکن اگر فنگس آپ کے پھیپھڑوں تک پہنچ جائے تو یہ جان لیوا ثابت ہو سکتی ہے۔
اڈیلیا کا کہنا ہے کہ ہوا میں فنگس کے ذرات سانس کے ذریعے ہمارے پھیپھڑوں تک پہنچتے ہیں اور وہاں بڑھنا شروع کر دیتے ہیں۔
انھوں نے کہا کہ ’صحت مند لوگ سنگین بیماریوں کا شکار نہیں ہوتے۔ لیکن فنگس کچھ مریضوں کے کمزور مدافعتی نظام کا فائدہ اٹھا سکتی ہے۔ ایسی صورتوں میں فنگس بہت زیادہ نقصان پہنچا سکتی ہے۔‘
یہی وجہ ہے کہ کووڈ وبائی مرض کے دوران میوکر مائکوسس جیسی فنگل بیماریوں کے واقعات میں اضافہ ہوا۔
لیکن فنگس کا ایک گروپ ہے جو نہ جلد پر اُگتا ہے اور نہ ہی پھیپھڑوں میں داخل ہوتا ہے۔ اس کے بجائے، وہ پہلے سے ہی جسم میں موجود ہے۔ یہ فنگس یا مولڈ خمیر کی ایک قسم ہے، جسے کینڈیڈیا آلبیکین کہا جاتا ہے۔
ایڈیلیا بتاتی ہیں کہ ’زیادہ تر صحت مند لوگوں کے معدے میں خمیر ہوتا ہے، جو ہاضمے میں مدد کرتا ہے۔ لیکن اکثر یہ خمیر پیٹ سے نکل کر خون میں گھلنے لگتا ہے، جس سے انفیکشن پھیلتا ہے۔‘
’یہ عام طور پر اس وقت ہوتا ہے جب جسم کا مدافعتی نظام کمزور ہو جاتا ہے یا جب کسی آپریشن یا چوٹ کی وجہ سے اعضا کو نقصان پہنچتا ہے تو فنگل انفیکشن ہو سکتا ہے۔‘
’اگر کینڈیڈیا انفیکشن خون میں داخل ہو جائے تو یہ ایک بیکٹیریل بیماری جیسی حالت کا باعث بنتا ہے۔ مریضوں میں سیپٹیسیمیا ہو جاتا ہے اور انھیں انتہائی نگہداشت میں علاج کروانا پڑتا ہے۔‘
لیکن اگر ہمارے ارد گرد اور ہمارے جسموں میں فنگس کی بہت سی اقسام ہیں تو وہ کبھی کبھار اتنی پریشانی کیوں پیدا کرتے ہیں؟
،تصویر کا ذریعہGetty Images
فنگل انفیکشنز
نائیجیریا کی لاؤس یونیورسٹی میں کلینیکل بیالوجی کی پروفیسر ریٹا اولوڈیلی کا کہنا ہے کہ فنگل انفیکشن کا بڑھتا ہوا پھیلاؤ ہر ایک کے لیے تشویش کا باعث ہے۔
’ہر ایک کو اس کی سنگینی کو سمجھنا چاہیے۔ کوویڈ کے دوران ہونے والے تجربے کو فراموش نہیں کیا جا سکتا۔‘
’پہلے کے مقابلے فنگل بیماری کے انفیکشن میں نمایاں اضافہ ہوا ہے۔ اس کی ایک وجہ زمین کا بڑھتا ہوا درجہ حرارت ہے۔ گرمی میں فنگل پیتھوجینز بہت آسانی سے بڑھتے ہیں۔‘
اس رپورٹ میں ہم گلوبل وارمنگ اور موسمیاتی تبدیلی پر بھی بات کریں گے لیکن اس سے پہلے ایک اور وجہ پر غور کرنا ضروری ہے۔
جیسے جیسے میڈیکل سائنس اور ٹیکنالوجی نے ترقی کی ہے ہماری عمر بڑھی ہے۔ لوگ اب زیادہ جی سکتے ہیں۔
لیکن کیا یہی وجہ ہے کہ ہم ایسی بیماریوں کا شکار ہو رہے ہیں؟
ریٹا اولوڈیلی بتاتی ہیں کہ یہ سب کیسے جڑا ہوا ہے۔
وہ کہتی ہیں کہ ’طبی ٹیکنالوجی نے اتنی ترقی کر لی ہے اور ایسی بہت سی دوائیں دستیاب ہیں کہ یہاں تک کہ شدید بیمار مریض یا کمزور مدافعتی نظام والے لوگ بھی اب زیادہ زندہ رہ سکتے ہیں۔‘
’ایسے لوگوں میں فنگل انفیکشن آسانی سے پھیل سکتا ہے جو مریض اعضا کی پیوند کاری کے لیے سرجری کرواتے ہیں مگر اس کے بعد ان کا مدافعتی نظام کمزور ہو جاتا ہے۔‘
’کینسر کے مریضوں کا مدافعتی نظام کیموتھراپی سے کمزور ہو جاتا ہے۔ ایسے مریضوں کو آسانی سے فنگل انفیکشن ہو سکتا ہے۔‘ لیکن پھر مغربی ممالک کے مقابلے جنوبی ممالک یعنی ایشیا، افریقہ اور لاطینی امریکہ کے غریب اور ترقی پذیر ممالک میں کیا صورتحال ہے؟
کیا وہاں ان بیماریوں کی تشخیص اور علاج کے لیے سہولیات کم ہیں؟
ریٹا اولاڈیلی کہتی ہیں کہ دونوں میں بہت فرق ہے۔
’ان ممالک میں فنگل بیماریوں کی تشخیص اور علاج دونوں کے لیے اینٹی فنگل ادویات کی کمی ہے۔ سب صحارا افریقہ میں دراصل ایڈز کے مریضوں کی ایک بڑی تعداد ہے۔ لیکن فنگل بیماریوں کے لیے کافی سہولیات موجود نہیں ہیں۔ یہی وجہ ہے کہ ان ممالک میں فنگل بیماریاں بڑھ رہی ہیں۔‘
وہ کہتے ہیں کہ ’فنگل انفیکشن گرم علاقوں اور ان ممالک میں زیادہ عام ہیں جہاں ایڈز یا ایچ آئی وی کا پھیلاؤ زیادہ ہے۔‘
’چونکہ ایڈز جسم کے مدافعتی نظام کو کمزور کرتا ہے، اس لیے یہ فنگس کے لیے پورے جسم میں پھیلنا آسان بنا دیتا ہے۔‘
گلوبل وارمنگ کی وجہ سے نہ صرف ان گرم علاقوں بلکہ شمالی ممالک میں بھی درجہ حرارت بڑھ رہا ہے اور اس کے ساتھ فنگل انفیکشن کا خطرہ بھی بڑھ رہا ہے۔

،تصویر کا ذریعہGetty Images
بڑھتا ہوا درجہ حرارت
امریکہ میں جان بلومبرگ سکول آف پبلک ہیلتھ میں آرتورو کاساڈیول مولیکیولر بائیولوجی اور امیونولوجی کے پروفیسر ہیں۔ آرتورو کا کہنا ہے کہ جیسے جیسے زمین کا درجہ حرارت بڑھے گا، فنگل انفیکشن ان جگہوں پر پھیل جائے گا جہاں وہ پہلے نہیں تھے۔
’تمام جاندار اپنے ماحول کے مطابق ڈھالنا سیکھتے ہیں۔ جیسے جیسے زمین کا درجہ حرارت بڑھتا ہے، بہت سی بیماریاں پھیل سکتی ہیں۔ جب درجہ حرارت نارمل ہوتا ہے، تو بہت سے جاندار ایسے ہوتے ہیں جو درختوں اور مٹی میں پروان چڑھتے ہیں۔‘
وہ کہتے ہیں کہ ’فنگس کی بیماریوں کا پھیلاؤ، جس کے بارے میں طبی سائنس کو قطعی طور پر کوئی علم نہیں ہے، بڑھتے ہوئے درجہ حرارت کے ساتھ بھی بڑھ سکتا ہے۔‘
موسمیاتی تبدیلی ایک بڑا موضوع ہے۔ ہمیں یہ بھی دیکھنے کی ضرورت ہے کہ کس قسم کا درجہ حرارت فنگس یا مولڈ کے بڑھنے کے لیے موزوں ہے۔
اس سے ہمیں یہ سمجھنے میں مدد ملے گی کہ مستقبل میں فنگس دنیا کے کن حصوں میں پھیلے گی۔
آرتورو کہتے ہیں کہ ’نمی یا ہوا میں پانی کے بخارات کا ہونا فنگس کے بڑھنے کے لیے ضروری ہے۔ جس طرح کھمبی بارش کے بعد جنگل میں گیلے ملبے پر اگتی ہے، اسی طرح فنگس بھی اس وقت اگتی ہے جب فضا میں نمی بہت ہو۔ جہاں زیادہ نمی ہوتی ہے، فنگس تیزی سے اگتی ہے۔‘
وہ کہتے ہیں کہ ’جیسے جیسے زمین کا درجہ حرارت بڑھتا جائے گا کچھ جگہوں پر صحرا پھیلتے جائیں گے، جب کہ دوسری جگہوں پر بہت زیادہ بارشیں ہوں گی۔ دونوں ہی پھپھوندی کی نشوونما کو متاثر کریں گے۔‘
مثال کے طور پر ’کوکسیڈ آوڈز ایمٹس نامی فنگس کی وجہ سے ہونے والی بیماری امریکہ کے جنوب مغرب کے صحراؤں میں پھیل رہی ہے۔‘
’جیسے جیسے صحرا پھیل رہا ہے، اس فنگس کی ذیلی اقسام بھی فنگس کے پھیلاؤ کو متاثر کر رہی ہیں۔ مختصر یہ کہ مرطوب ہوا اور موسمیاتی تبدیلیاں فنگس کے پھیلاؤ کو متاثر کر رہی ہیں۔‘
آرتورو اور ان کی ٹیم نے اپنی تحقیق سے ایک ماڈل بنایا ہے۔
اس سے پتہ چلتا ہے کہ گرم علاقوں میں اگنے والی فنگس ٹھنڈے علاقوں میں اگنے والی پھپھوندی کے مقابلے میں بڑھتے ہوئے درجہ حرارت کے مطابق زیادہ موافق ہوتی جا رہی ہے۔
اس کا مطلب یہ ہے کہ پھپھوندی موسموں کی بنیاد پر خود کو تبدیل کر سکتی ہے، اور یہ پوری دنیا میں ہو سکتی ہے۔ اس لیے جسم کا درجہ حرارت بھی باہر کی ہوا کے درجہ حرارت کے ساتھ بدل رہا ہے۔ اب انسانی جسم پہلے سے زیادہ ٹھنڈا ہونے لگا ہے۔
پہلے ہمارے جسم اتنے گرم تھے کہ ان میں پھپھوندی کا بڑھنا مشکل تھا۔ لیکن پچھلی چند دہائیوں میں انسانی جسم کے درجہ حرارت میں کمی آئی ہے۔
آرٹورو بتاتے ہیں کہ ’ہمارے جسم کا درجہ حرارت عام طور پر 37 ڈگری سیلسیس کے ارد گرد ہوتا ہے۔ اس درجہ حرارت پر پھپھوندی کا بڑھنا مشکل ہوتا ہے۔‘
’یہی وجہ ہے کہ جن لوگوں کو فنگل انفیکشن ہوتا ہے ان میں بھی بنیادی طور پر ناخنوں کے نیچے انفیکشن ہوتا ہے، کیونکہ وہاں کا درجہ حرارت نسبتاً کم ہوتا ہے۔‘
آرٹورو نے نوٹ کیا کہ انسانی جسم کا اوسط درجہ حرارت سو سال پہلے کے مقابلے میں اب ایک ڈگری کم ہو گیا ہے۔
یہی وجہ ہے کہ لوگ اب فنگل بیماریوں کا زیادہ شکار ہو رہے ہیں۔ پہلے لوگوں کو تپ دق اور دیگر متعدی امراض لاحق ہوتے تھے جس کی وجہ سے جسم میں سوجن ہو جاتی تھی اور جسم کا درجہ حرارت بڑھ جاتا تھا۔
اب جدید ادویات کی مدد سے ان بیماریوں پر قابو پا لیا گیا ہے اور جسم کا درجہ حرارت بھی کم ہو گیا ہے۔ جس کی وجہ سے فنگل بیماریوں کا پھیلاؤ آسان ہو گیا ہے۔
لیکن جیسا کہ زمین کا درجہ حرارت مسلسل بڑھ رہا ہے، ہم خود کو ان بیماریوں سے کیسے بچا سکتے ہیں؟

،تصویر کا ذریعہGetty Images
فنگس سے بچاؤ
فنگل بیماریوں کے علاج کے لیے استعمال ہونے والی دوائیں بنیادی طور پر ایزول کہلاتی ہیں۔ وہ زراعت کے ساتھ ساتھ ادویات میں بھی استعمال ہوتی ہیں۔ لیکن ان کیمیکلز کا استعمال اب اس حد تک بڑھ گیا ہے کہ پھپھوندی نے ان سے خود کو بچانا سیکھ لیا ہے۔
برطانیہ کی مانچسٹر یونیورسٹی میں فنگل امراض کے پروفیسر مائیکل بروملے بتاتے ہیں کہ ’عام طور پر ہسپتالوں میں فنگس کی بیماریوں کے علاج کے لیے ایزول دوائیں استعمال کی جاتی ہیں۔‘
ان کا مزید کہنا ہے کہ ’لیکن ہم نے محسوس کیا ہے کہ یہ دوائیں فنگس کے خلاف اب اتنی موثر نہیں ہیں جتنی کہ پہلے ہوتی تھیں۔ کیونکہ ان کی ان ادویات کے خلاف مزاحمت کرنے کی صلاحیت تیزی سے بڑھ رہی ہے۔‘
’یہ ماحول میں فنگسائڈز یا اینٹی فنگل ادویات کی مقدار میں بہت زیادہ اضافے کی وجہ سے ہوا ہے۔ فصلوں کو فنگس سے بچانے کے لیے ان ادویات کا بڑی مقدار میں سپرے کیا جاتا ہے۔‘
جیسے جیسے زراعت میں فنگسائڈز کا استعمال بڑھتا گیا، فنگس نے ان ادویات سے نمٹنے کا طریقہ بھی سیکھا۔
ان میں سے ایک آسپرگیلس نامی فنگس ہے جو خوراک کو خراب کرنے اور گلنے سڑنے کا سبب بنتی ہے۔
مائیکل بروملے کہتے ہیں کہ ’یورپ کے فارموں پر ہر سال دس ہزار ٹن فنگسائڈز کا سپرے کیا جاتا ہے۔ فنگسائڈز کے وسیع پیمانے پر استعمال کی وجہ سے اس فنگس نے فنگسائڈز کے خلاف مزاحمت کرنے کی صلاحیت پیدا کر لی ہے۔ اس لیے، جبکہ ایزولز کو ہسپتالوں میں فنگل بیماریوں کے علاج کے لیے استعمال کیا جاتا ہے، لیکن ان ادویات کا آسپرگیلس پر زیادہ اثر نہیں ہوتا ہے۔‘
تو اب اس کا حل کیا ہے؟ مائیکل بروملے کا کہنا ہے کہ کچھ لوگ کھیتوں میں فنگسائڈز کے استعمال پر پابندی کا مطالبہ کر رہے ہیں۔
لیکن ایسا کرنے سے فصلوں کو شدید نقصان پہنچے گا اور خوراک کی پیداوار میں کمی آئے گی۔
بروملے نے خود ان ادویات کے متبادل تلاش کرنے کی کوشش شروع کر دی ہے۔ ان کا دعویٰ ہے کہ اس نے جو کیمیکل تیار کیے ہیں وہ فنگس کے ڈی این اے کو متاثر کرتے ہیں اور فنگل کے خلیوں کو بڑھنے سے روکتے ہیں۔
فوسمانومی پکس ایک کیمیکل ہے جو فنگس کو روک سکتا ہے۔ یہ دیگر اینٹی فنگل ادویات سے قدرے مختلف ہے۔
بروملی کا کہنا ہے کہ ’اس کے اینکرز فنگل سیل میں پروٹین سے منسلک ہوتے ہیں۔ جب دوا موثر ہوتی ہے، تو پروٹین وہاں نہیں پہنچ پاتے جہاں انھیں جانے کی ضرورت ہوتی ہے۔ اس لیے فنگل سیلز زندہ نہیں رہ سکتے۔‘
محققین کا کہنا ہے کہ یہ دوا آئندہ چند سالوں میں مریضوں کے لیے دستیاب ہو گی۔
آسپرگیلوسیس ایک خطرناک بیماری ہے جو ہر سال ہزاروں افراد کو ہلاک کرتی ہے۔ یہ اس فنگس سے جو مٹی اور ہوا میں پائی جاتی ہے سے جنم لیتی ہے اور انسانوں کے پھیپھڑوں میں داخل ہوتی ہے۔
لیکن اگر ہم نئی دوائیں استعمال کرکے اس فنگس کو ماحول میں پھیلنے سے روک سکیں تو بہت فائدہ ہوگا۔
اب اپنے اصل سوال کی طرف واپس چلتے ہیں۔ کیا ہم فنگس کے پھیلاؤ کو روک سکتے ہیں؟
کچھ فنگل بیماریاں عام ہیں۔ لیکن کچھ جان لیوا بھی ہو سکتی ہیں۔ فنگل بیماریوں کی تشخیص یا پہچان مشکل ہے کیونکہ ان کی علامات بہت سی دوسری بیماریوں سے ملتی جلتی ہیں۔
بڑھتی ہوئی آبادی کے ساتھ خوراک کی طلب بڑھ رہی ہے اور اس کو پورا کرنے کے لیے فصلوں کی حفاظت ضروری ہے۔ اس لیے فنگسائڈز کا استعمال ضروری ہو گیا ہے۔
اس لیے فنگل بیماریوں پر قابو پانا یقینی طور پر ممکن ہے، لیکن یہاں سوال یہ ہے کہ کیا ہم اسے جلدی کر سکتے ہیں؟










